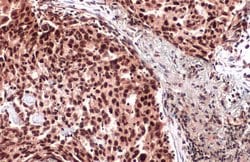
Invitrogen ATRX Polyclonal Antibody 100 &mu;L; Unconjugated:Antibodies,

missing translation for 'onlineSavingsMsg'
Learn More
Learn More
Invitrogen™ ATRX Polyclonal Antibody


Rabbit Polyclonal Antibody
Brand: Invitrogen™ PA521348
This item is not returnable.
View return policy
Description
Recommended positive controls: 293T, A431, HeLa, HepG2, NIH3T3, PC-12, Rat-2. Predicted reactivity: Mouse (97%), Chimpanzee (100%). Store product as a concentrated solution. Centrifuge briefly prior to opening the vial.
ATRX encodes a protein that contains an ATPase/helicase domain, and thus it belongs to the SWI/SNF family of chromatin remodeling proteins. The mutations of this gene are associated with an X-linked mental retardation (XLMR) syndrome most often accompanied by alpha-thalassemia (ATRX) syndrome. These mutations have been shown to cause diverse changes in the pattern of DNA methylation, which may provide a link between chromatin remodeling, DNA methylation, and gene expression in developmental processes. This protein is found to undergo cell cycle-dependent phosphorylation, which regulates its nuclear matrix and chromatin association, and suggests its involvement in the gene regulation at interphase and chromosomal segregation in mitosis. Multiple alternatively spliced transcript variants encoding distinct isoforms have been reported.
Specifications
| ATRX | |
| Polyclonal | |
| Unconjugated | |
| ATRX | |
| 4833408C14Rik; AI447451; alpha thalassemia/mental retardation syndrome (X-linked); alpha thalassemia/mental retardation syndrome X-linked; alpha thalassemia/mental retardation syndrome X-linked (RAD54 homolog, S. cerevisiae); alpha thalassemia/mental retardation syndrome X-linked homolog; alpha thalassemia/mental retardation syndrome X-linked homolog (human); ATP-dependent helicase ATRX; ATR2; ATRX; ATRX, chromatin remodeler; DNA dependent ATPase and helicase; DXHXS6677E; helicase 2; helicase 2, X-linked; helicase II; heterochromatin protein 2; HP1 alpha-interacting protein; Hp1bp2; Hp1bp38; HP1-BP38; HP1-BP38 protein; JMS; mental retardation, X-linked 52; MRX52; MRXHF1; MRXS3; pABP-2; Rad54; RAD54L; RP5-875J14.1; SFM1; SHS; transcriptional regulator ATRX; XH2; X-linked helicase II; X-linked nuclear protein; XNP; Zinc finger helicase; Znf-HX | |
| Rabbit | |
| Antigen affinity chromatography | |
| RUO | |
| 22589, 246284, 546 | |
| Store at 4°C short term. For long term storage, store at -20°C, avoiding freeze/thaw cycles. | |
| Liquid |
| Immunohistochemistry (Paraffin), Immunoprecipitation, Western Blot, Immunocytochemistry | |
| 0.27 mg/mL | |
| PBS with 1% BSA, 20% glycerol and 0.025% ProClin 300; pH 7 | |
| P46100, P70486, Q61687 | |
| ATRX | |
| Recombinant protein encompassing a sequence within the C-terminus region of human ATRX. The exact sequence is proprietary. | |
| 100 μL | |
| Primary | |
| Human, Mouse, Rat | |
| Antibody | |
| IgG |
Product Content Correction
Your input is important to us. Please complete this form to provide feedback related to the content on this product.
Product Title
Spot an opportunity for improvement?Share a Content Correction